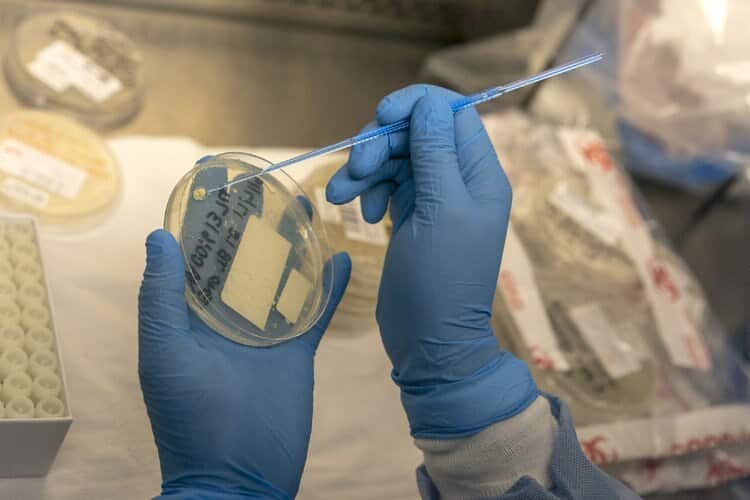
New TB Vaccine Could Save Millions of Lives, Study Suggests

Born in the foothills of southern Nepal to a humble family with a humble background, Ram Bhusal never imagined he would end up leading the life he currently is.
Bhusal is a postdoctoral research fellow investigating ticks, which he says cost Aussie cattle farmers of about $300 million a year, as well as an important figure in current tuberculosis (TB) research, helping to determine how the bacterium survives in the body.
Dr Bhusal and his team of scientists from the University of Auckland and Victoria University of Wellington are exploring exactly how the tuberculosis bacterium survives in the human body for so long before striking - the most common way it affects more than 1,400 people in Australia.
This condition is known as latent TB.
“For people born in Australia, TB is a very rare occurrence at less than one in 100,000. But for people born overseas, like those from countries like Nepal, Bangladesh and the subcontinent, they are at a higher risk of getting TB infection, in the form of latent TB,” says Dr Justin Denholm the Medical Director of the Victorian Tuberculosis Program.
“Most organisms thrive when their food source is abundant, and in many cases, this food is in the form of glucose. But, in the case of the TB bacterium, it can switch the source of energy according to the situation - glucose or fatty acids,” Dr Bhusal says of his research.

The bacterium possesses a unique to remain in a state of hibernation for decades before eventually becoming active.
“These bacteria live in areas known as macrophages - where there is no glucose but only fatty acids available. My work was about finding how this works,” he says.
Although an enzyme had been known in the scientific circle for almost two decades, it was not known how the bacteria actually survive without showing any symptoms. Dr Bhusal explored that avenue before reaching a breakthrough.
But it could be decades away before we see any tangible results in everyday life, says Dr Denholm.
“Every new initiative like these must be applauded, but it will be a long time before we will be able to see it making an impact in the lives of people who suffer from latent TB,” he says with cautious optimism.

Bhusal says it has opened up opportunities for others to work further.
“I always say it has opened a road. This is the first stage, I hope one day my work will save lots of pain and suffering. That would be satisfying, to say the least,” he told SBS Nepali.
People from migrant backgrounds, particularly those from the subcontinent where TB is much more prevalent with almost 45 per cent penetration, have a higher risk of TB infection.
“The Mycobacterium tuberculosis, which might have remained latent in the body of host for years, can get activated when [a person’s] immunity is at its lowest. Australia is one of the few countries that are best prepared to deal with TB, so while people shouldn’t be alarmed, they definitely need to be aware that they could be a carriage of the TB. A simple blood test can help.”
From TB to ticks
In his present-day role at Monash University as a Postdoctoral Research Fellow, he is looking into ticks which he says is wipes about $300 million annually from Australian livestock farmers’ income.
“Australian paralysis ticks affect beef and milk producers as their cattle become the hosts,” explains Bhusal.
“Normally if a bug like mosquito bites, you immediately know,” he says. “But this is not so when a tick bites, and they can keep sucking the blood for weeks without any interruptions. This is because when the ticks bite, they release a protein which blocks out the immune system from detecting the bites.”
He has now characterised these proteins, which he hopes will lead to the development of anti-inflammatory drugs.
More to learn

Having already created a few ripples in his research fields, Ram Bhusal is not done yet.
“I am still learning - there are many more things I want to learn. I am still a novice,” he says.
Bhusal, who spends a considerable amount of time studying in Korea, New Zealand and now in Australia, wants to return home in Nepal.
“I feel there is so much one can do from a place like Nepal, but I need to be well equipped too. Hence, there are a few boxes I would like to tick before I go back home.”
Inspiration to other migrants?

Asked about the current generation of international students here in Australia, and whether he has noticed any pressing issues within the cohort, Bhusal says he has noticed a lot of lack self-confidence in some students.
“I think, a lot of international students, who could be top of the cream, somehow have allowed their self-confidence to evaporate, and that is the biggest issue I have seen,” he says.
He counsels that those students should be steadfast in pursuing their goals.
“Consistency is key. I also studied in Nepal, in far different conditions than available here in Australia, I think if you are true to your intentions, you can make the cut.
“You need to follow a path and keep walking continuously until the objective is realised.”
